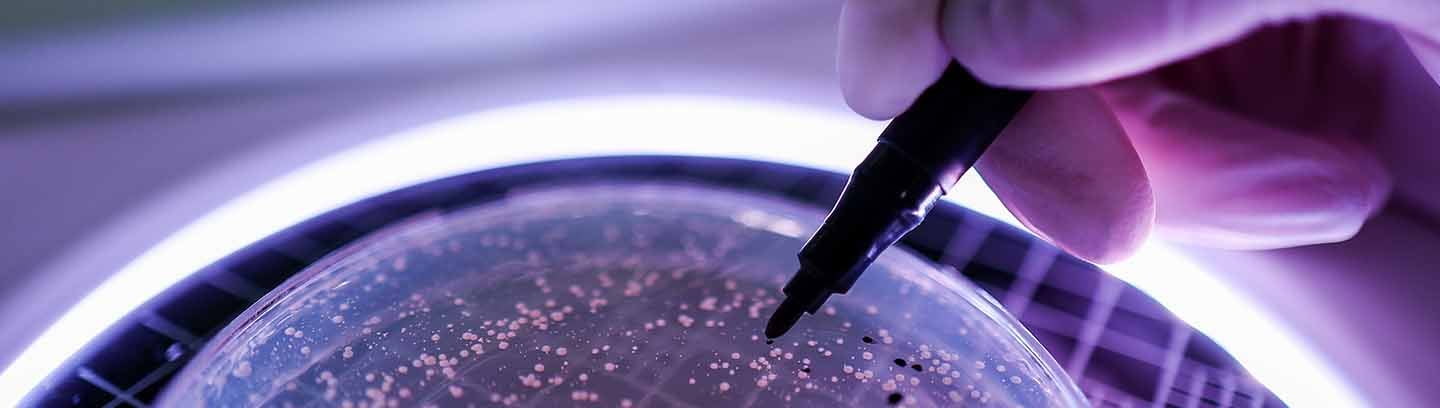

Through seven CEO roundtables hosted in partnership with AusBiotech last month, we brought together industry leaders to explore what’s working, identify the gaps, and discuss how targeted support could unlock even greater potential. The insights shared here reflect our own takeaways from these discussions.
What’s clear is that the foundations are strong – skilled talent, cutting-edge research, and a thriving early-stage ecosystem. The challenge is to connect these strengths with the funding, policy, and commercial pathways that will help businesses scale and compete globally. With the right collaboration, Australia is well placed to become more than a hub for innovation, but a leader in turning discoveries into commercial success.
A fragmented funding landscape
The roundtable highlighted that the current government funding landscape is complex and fragmented, making it challenging for some biotech companies to access the support they need. Government support remains heavily weighted towards the early stages of research and development (R&D). However, limited access to scale-up funding is creating a widening gap for companies progressing from discovery to commercialisation.
This gap is compounded by cautious private investment, with a low-risk appetite due to the long development timelines, regulatory complexity and high capital requirements inherent to biotech. This hesitancy is particularly challenging for companies transitioning from early-stage innovation to product development and commercialisation.
Bringing greater coordination and accessibility to the funding landscape would unlock growth for individual companies and strengthen the sector. In the meantime, companies can benefit from carefully structured approaches that blend government support, private investment, and strategic partnerships, helping them build resilient funding models, drive growth, and translate innovation into global opportunity.
Policy and regulatory disconnects
The roundtable discussions highlighted the importance of building deeper biotech expertise within government. With a stronger understanding of the sector, policy design and grant assessments can better align with the practical realities of biotech, helping companies scale more effectively.
The ASX was also encouraged to continue building knowledge of biotech business models, which can enhance investor confidence and smooth listing pathways.
In this context, companies can take proactive steps by engaging early with regulators, clearly articulating the operational realities of their business, and contributing to industry-led policy discussions – ensuring they maximise support, influence decisions, and create a pathway for sustainable growth.
Commercialisation and intellectual property (IP) strategy
As companies mature, commercialisation challenges are becoming more evident. IP strategies are often not fully developed, creating a risk of losing value overseas. Many firms aspire to manufacture onshore, but clearer pathways are needed around feasibility, supply chain planning, and regulatory frameworks.
Global expansion also hinges on balancing clinical trials at home and abroad. While Australia remains a favourable environment for early-stage trials, international studies are often necessary to secure global market access. Thoughtful planning, combined with advisory support, can help companies navigate these transitions efficiently, optimise global operations, and translate innovation into scalable commercial outcomes.
Talent and incentives
Attracting and retaining talent remains a top priority. Employee share schemes and targeted tax incentives for remuneration
are essential tools for competing with larger international players, helping companies attract high-calibre staff and align team performance with long-term business goals.
Flexible and competitive incentives will be critical to building and sustaining the workforce required to support long-term growth. By carefully structuring equity plans and remuneration strategies, companies can align talent incentives with business objectives and investor expectations, helping ensure they retain the people needed to drive success.
Unlocking the next stage of growth
The roundtables reinforced that Australia’s biotech sector has a strong foundation and enormous opportunity. To realise this potential, greater alignment across funding, policy, and commercialisation is essential, so that innovation can translate into global impact.
Whether you’re navigating complex funding pathways, engaging with regulators, or planning for international growth, we can help you find the right strategy to move forward with confidence. By combining financial and strategic expertise, we can help you unlock opportunities and ensure Australia continues to thrive on the global stage.
Learn more about how our Life Sciences services can help you